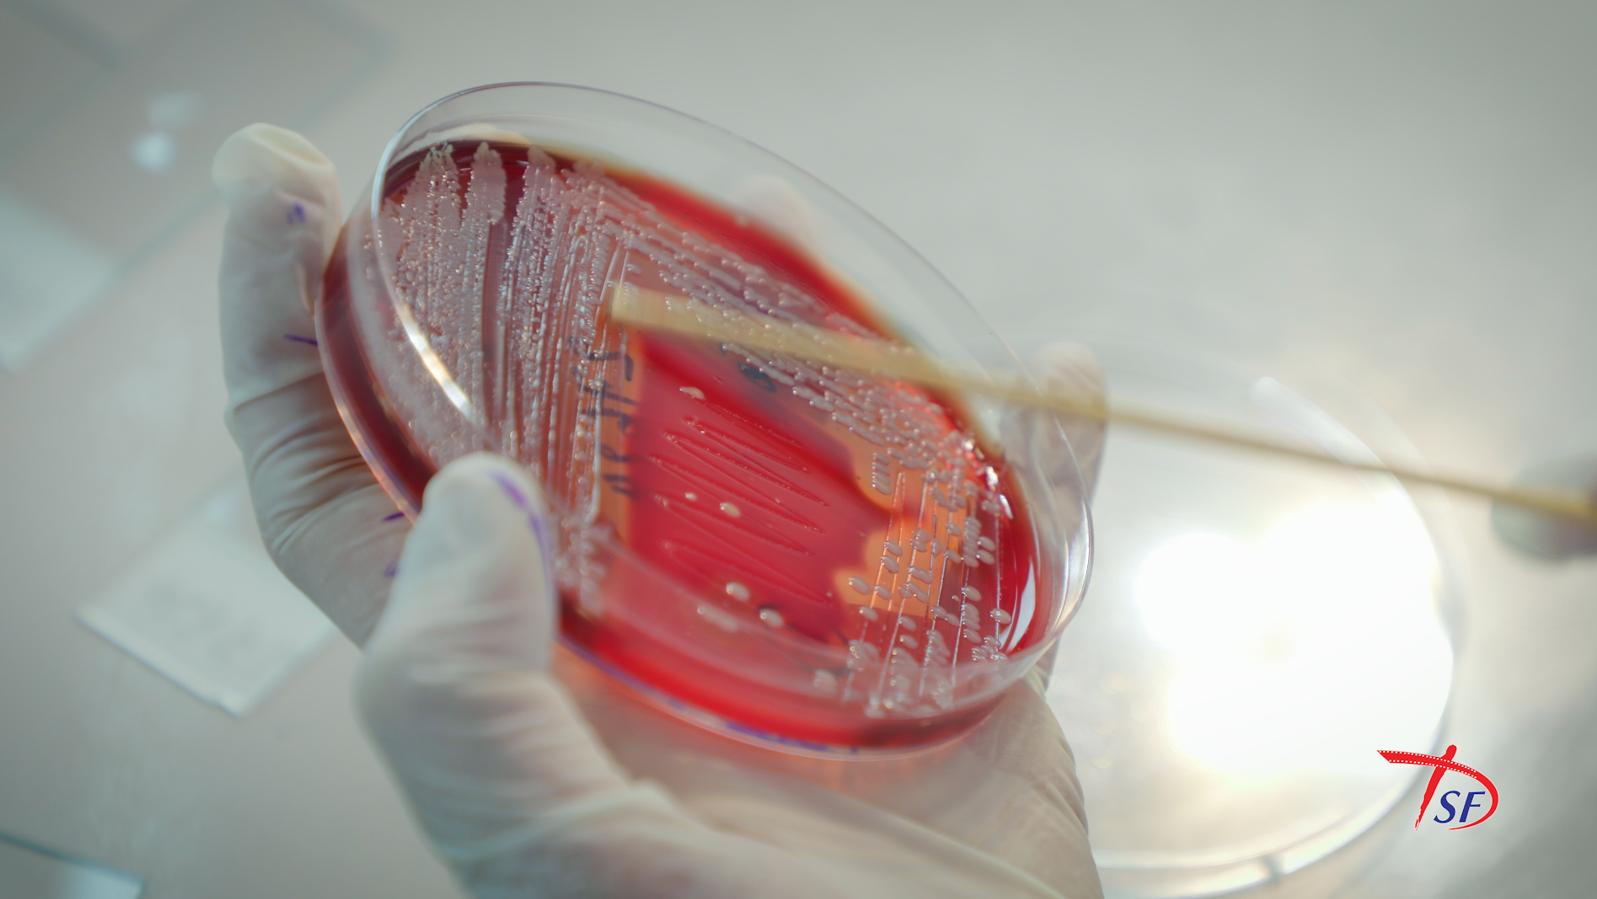
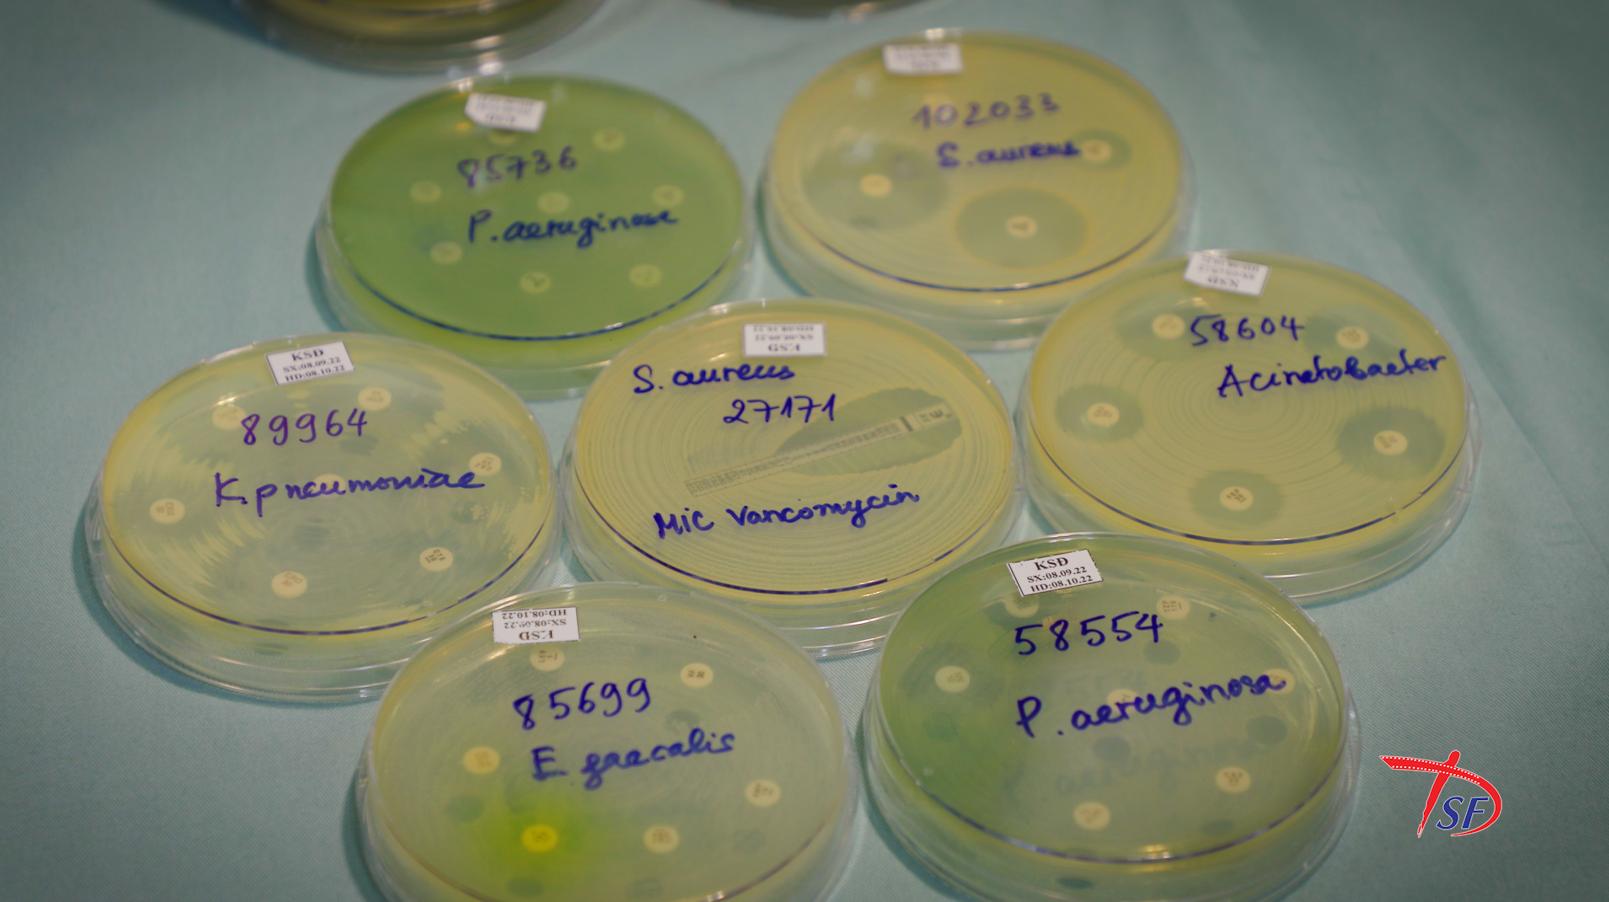

Kháng thuốc kháng sinh
KHÁNG THUỐC KHÁNG SINH / ANTI-ANTIBIOTICS
KHÁNG THUỐC KHÁNG SINH / ANTI-ANTIBIOTICS
Đơn vị sản xuất/Production: Công ty TNHH MTV Hãng phim Tài liệu và Khoa học Trung ương / National Documentary and Scientific Film Studio LLC
Năm sản xuất/Year: 2023
Thời lượng/Duration: 32 phút 01 giây
Phân loại phim/Classification: P
Đạo diễn/Director: Hoàng Hà Lê
Biên kịch/Screenwriter: Đoàn Minh Anh – Nguyễn Sỹ Hảo
Đạo diễn hình ảnh/Director of Photography: Đào Đức Thanh
Âm thanh/Sound: Đào Đức Thanh
Tóm tắt/Synopsis:
Thực trạng kháng kháng sinh ở Việt Nam đã ở mức báo động, gây khó khăn và những hậu quả nghiêm trọng trong quá trình điều trị bệnh. Đây không chỉ là thách thức lớn của y học mà còn là vấn đề đáng báo động của toàn xã hội. Người dân cần nâng cao sự nhận thức về kháng sinh và kháng thuốc kháng sinh.
Antibiotic resistance in Vietnam has reached an alarming level, causing serious difficulties and consequences in medical treatment. This is not only a major challenge for the healthcare sector but also an urgent issue for society as a whole. Awareness needs to be raised among the public about antibiotics and the dangers of antibiotic resistance.
 Đạo diễn/Director’s biography:
Đạo diễn/Director’s biography:
Đạo diễn Hoàng Hà Lê sinh năm 1990, tốt nghiệp chuyên ngành Đạo diễn Truyền hình trường Đại học Sân khấu – Điện ảnh Hà Nội. Các tác phẩm tiêu biểu: Hai phía cuộc đời, Mỗi giọt máu cho đi – một cuộc đời ở lại, Nhật ký của ba, Làng xây đảo, Tâm tình của gốm, Khát vọng vươn xa, Phía sau ánh hào quang, Hai giọt nước, Cô đỡ thôn bản, Chầu văn âm hưởng linh thiêng, Kháng thuốc kháng sinh, Cây trồng biến đổi gen…
Director Hoang Ha Le, born in 1990, graduated with a major in Television Directing at Hanoi Academy of Theatre and Cinema. Her notable works include Hai phía cuộc đời, Mỗi giọt máu cho đi – một cuộc đời ở lại, Nhật ký của ba, Làng xây đảo, Tâm tình của gốm, Khát vọng vươn xa, Phía sau ánh hào quang, Hai giọt nước, Cô đỡ thôn bản, Chầu văn âm hưởng linh thiêng, Kháng thuốc kháng sinh, Cây trồng biến đổi gen…